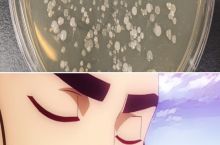

Trending Videos
Next Posts

If I was a technical support guy

Not efficient enough

Yeah… I don’t want to pet him

Absolute stupidity.

Kek

Chika Is Hisoka Confirmed

This is getting annoying.

When a gamer passes a woman:

Businessman

Maybe it’s a little dark

a weird horse now innit?

Kanna's Words Of Wisdom

Posting memes until I get my master's degree day 303 meme 505

Character growth

Together we are united.

I got a migraine and thought of this

We’re all doomed

Let's celebrate it together : D

tHeY DoNt lYk THaT mILk

The Yanks are coming! The Yanks are coming! ….at our own pace though

Because it fights prostate cancer

Come on, people

My friend's pet is very shy, specially around other dogs. Today was his first doggy day care. This is the photo the dog sitter sent to him. Guess where he is in the photo?

Girls dicks

I already miss Summer.

RE?

wonder if they ever hired him?

Yes Netflix, I’m going to cry.

Noice

you're safe now, be happy

Accurate very accurate

We are better than them in everything

We made corn on the cob and spotted this great review

The greatest mystery of our time

Trotsky sure had fun in exile before he got assassinated!

Amogus-Bots

How many times do you do it everyday?

Truly the ultimate defense against the heat of 1,000 Suns.

Hmmm...I think i have seen her somewhere..

I had to made this

I feel like a such a boomer making memes like this

scribble

What can I say? He loved his nukes!

What huge balls look like

They always become the victim

There goes Buck Franklin, the impeccably well dressed lawyer who practices law out of a tent

I made a meme

Bzzzzbzzzzbzzzz*pok*

Hear ye! Hear ye! I come from Prequelmemes with a proposition!

Yer a sith harry

Only few will remember this August 8

Anal Hairy midget

UwU

My rental car has a "ram the guy in front of you" button

argue or whatever, it'll happen anyways.

So they make this in my country..... Which is in Africa

It’s funny right ?

Grow legs today!

Quench pls

I’ll do so as much as I can and hope this will not end in a ban

What’s PEMDAS ? All I know is BODMAS.

yes this is a personal attack

brehs

You are my sunshine

"eNhAnCeD aNd ExPaNdEd"

Hopefully this isn’t just me

mY nAmE is CYucagXzdh

Ika and her grandpa

And now all is equal

A Flawed Argument - Ink Drawing

I just wanted to sleep tho

Cat owner can relate

If its urgent...

Mad Scientist Finally Solves “Is She Into You, or Is She Just Being Polite?”


*** parking ticket


On second thought. Never mind

Online Job Interview

In Europe this is nothing.


My nephew decided to pour water all over the floor. Heres a picture my sister sent me

BIG SAD :(

Wink one eye at a time, checkmate

to be fair it sounds different in Arabic

Haha chocolate

Jesus Christ dancing break to impress his friends, 20 AD

They tried…

Nein ;_;
Forgive the Microbiology pun

Basically

Double standards

Must have been a bruh moment

What if we can’t just be anonymous anymore?

Haha thanks for reminding me :')

Finally the elexir of life

No lies detected

Arigato! Astolfo

6.9 times larger nice.

Here is a meme about game ads


 298,128
298,128